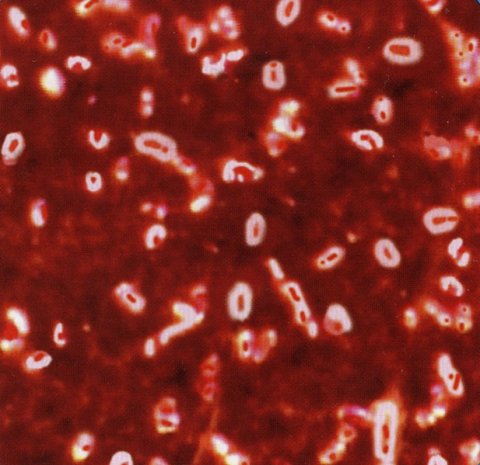

Bakteria broniąca się niemal przed wszystkimi antybiotykami spowodowała śmierć mieszkańca Belgii. Prawdopodobnie przybyła z Indii, a tworzą ją zmutowane szczepy zarazków Klebsiella pneumoniae i Escherichia coli.
Bakteria została odkryta w ostatnim kwartale 2010 roku przez Brytyjczyków. Swoją niepowtarzalną oporność na antybiotyki zawdzięcza enzymowi New Delhi Metallo-1. Nazwa przypisana przez Brytyjczyków oburzyła mieszkańców Indii, gdyż wskazuje stolicę Indii jako potencjalne źródło globalnego niebezpieczeństwa.
Należy wspomnieć, że w Indiach jest bardzo łatwy dostęp do wszelkiego rodzaju antybiotyków. Dla ludzi zamożnych i turystów są one dostępne bez recepty, stąd mogło tam dojść do rozprzestrzeniania się bakterii. Jednak indyjski Minister Zdrowia uważa to za złośliwą propagandę przeciwko jego krajowi, gdyż w ostatnim czasie dużo brytyjczyków było pacjentami indyjskich oddziałów, klinik medycznych. Wszystko ze względu na to, że w ich kraju różnorodne zabiegi są o wiele tańsze niż w Wielkiej Brytanii.
Chcąc pomóc rozwiązać problem musimy przyjrzeć się nie tylko lekarzom i pacjentom, ale całemu środowisku. Coraz częściej i więcej antybiotyków jest dodawanych do pasz zwierząt (stymulujących ich wzrost), są także rozpylane w formie areozolu, w celu ochrony warzyw, owoców przed szkdnikami. Tak naprawdę niewielkie dawki tych substancji, zawarte w areozoloach, są zbyt małe, żeby zwalczyć infekcje, natomiast wystarczające, by zlikwidować wrażliwe szczepy i zapoczątkować rozwój ich opornych odmian.
Pamiętać należy o domach i mieszkaniach - nie są one salą operacyjną, gdzie musi być sterylnie! Mikroorganizmy muszą żyć w pewnej równowadze, jeżeli wyjałowimy otoczenie, doprowadzi to powstania pustej przestrzeni, którą szybko zasiedlą kolonie oporne na różnorodne lekarstwa.
Źródło: polityka.pl / własne